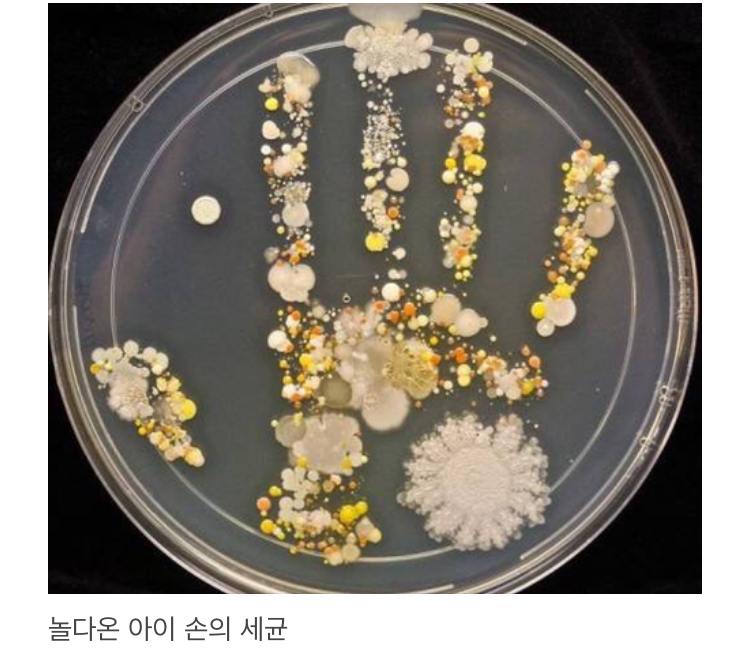

| 단축 URL: https://humoruniv.com/pds1033936 URL 복사 |
추천되었습니다.
|
|
| ▲ 다음글 | 사퇴를 다짐할 정도로 심한 폭언을 한 상사 .jpgg | 스푸키o |
|
2021-01-26 [10:33] |
| ▼ 이전글 | 삼성전자 7700만원 투자함 | 남산동설렁탕집 |
|
2021-01-26 [10:25] |
 답글 베스트
답글 베스트
|
답글 베스트1 |
앵무새마스터 |
맨 위 짤이 제일 재밌는거 같은데 더 없어?? [11]
|
117 0 |
|
2021-01-26 00:53 |
||||
|
답글 베스트2 |
야매상담사 |
진심 재밌네ㅋㅋㅋㅋ 근데 왜 한장밖에없음?
|
36 0 |
|
2021-01-26 00:53 |
||||

답글마당 (26)
|
|
앵무새마스터 |
맨 위 짤이 제일 재밌는거 같은데 더 없어??
|
1170 |
|
2021-01-26 |
||||||
오듀 |
누님...??
|
30 |
|
2021-01-26 |
|||||||
|
|||||||||||
낄때껴 |
재밌는 사진 잘 보았습니다.. 근데 밑에 잡다구리한 사진들은 뭐죠??
|
80 |
|
2021-01-26 |
|||||||
북괴저그 |
Alivya V Free 와 겨우 찾았네
|
171 |
|
2021-01-26 |
|||||||
꼽냐꼽다 |
ㅇㄷ
|
00 |
|
2021-01-26 |
|||||||
숫나물 |
와드 특) 찍어놓고 안찾아봄
|
00 |
|
2021-01-26 |
|||||||
|
|||||||||||
오듀 |
와드
|
00 |
|
2021-01-26 |
|||||||
쌈자를몰라아 |
ㅇㄷ
|
10 |
|
2021-01-26 |
|||||||
아니그게그러니까 |
de
|
00 |
|
2021-01-26 |
|||||||
asun |
짤 ㅇㄷ
|
00 |
|
2021-01-26 |
|||||||
넌안내냐 |
ㅇㄷ
|
00 |
|
2021-01-26 |
|||||||
엔필드 |
진짜 고급스럽고 우아하게 섹시하다...츄릅
|
00 |
|
2021-01-26 |
|||||||
|
|
야매상담사 |
진심 재밌네ㅋㅋㅋㅋ 근데 왜 한장밖에없음?
|
360 |
|
2021-01-26 |
||||||
|
|
마트이야기 |
이런거 넘 좋다
|
20 |
|
2021-01-26 |
||||||
|
|
앵무새o |
딸기 징그러
|
10 |
|
2021-01-26 |
||||||
|
|
26세운동하려는남 |
은행털려면 탱크있어야겠네
|
10 |
|
2021-01-26 |
||||||
|
|
벤드레드 |
소금광산 같은 곳가보고싶다
|
20 |
|
2021-01-26 |
||||||
|
|
프로지각러 |
감자창고 저거 강원도 은행금고모습아니냐..?보여줘도 되는건가
|
30 |
|
2021-01-26 |
||||||
|
|
수타발발 |
비행기에서 본 일식 멋지네
|
00 |
|
2021-01-26 |
||||||
|
|
흰둥흰둥흰둥이 |
아이 손 세균이랑 딸기 ㅠㅠㅠㅠㅠㅠㅠㅠㅠ 여권 사진찍는 아기는 어디있나 한참 봄ㅋ
|
00 |
|
2021-01-26 |
||||||
|
|
작성자고라니 |
신기해요~
|
00 |
|
2021-01-26 |
||||||
|
|||||||||||
|
|
만물좆물박사 |

어시!
|
20 |
|
2021-01-26 |
||||||
|
|
쫀득쫀득찹쌀떡 |
물방울 하나의 원자를 일렬로 잇기만 해도 지구에서 태양까지 간다는데 원자가 눈에 보인다는게 좀 이상하지 않음?
|
01 |
|
2021-01-26 |
||||||
|
|
Netflix |
오로라 야하네요
|
00 |
|
2021-01-26 |
||||||
|
|
BlackLP |
원자가 생각보다 큰데
|
10 |
|
2021-01-26 |
||||||
|
|
강남피부과1 |
ㅇㄷ
|
00 |
|
2021-01-26 |
||||||
 상대방에 대한 배려는 네티켓의 기본입니다.게시물에 상관없는 답글이나 추천유도성 답글을 달지 마세요.
상대방에 대한 배려는 네티켓의 기본입니다.게시물에 상관없는 답글이나 추천유도성 답글을 달지 마세요.
 스포일러성 답글이 신고되거나 발견되면 이유불문 삭제 혹은 정학처리 됩니다. 유의 부탁 드립니다.
스포일러성 답글이 신고되거나 발견되면 이유불문 삭제 혹은 정학처리 됩니다. 유의 부탁 드립니다.
| ▲ 다음글 | 사퇴를 다짐할 정도로 심한 폭언을 한 상사 .jpgg | 스푸키o |
|
2021-01-26 [10:33] |
| ▼ 이전글 | 삼성전자 7700만원 투자함 | 남산동설렁탕집 |
|
2021-01-26 [10:25] |

(주)웃긴대학재단 | 사업자등록번호 107-81-76979 | 서울시 송파구 충민로 66, 제와이-2123호 (문정동, 가든파이브라이프) | Fax 02-6280-9094
대표이사 이정민 | 개인정보 보호책임자 이정민 | 민원, 운영자메일, 관리안내 | 통신판매업신고 제 2010-서울강남-01011호
Since 1998.8.24, Copyright (c) 2025 humoruniv.com All right reserved.
대표이사 이정민 | 개인정보 보호책임자 이정민 | 민원, 운영자메일, 관리안내 | 통신판매업신고 제 2010-서울강남-01011호
Since 1998.8.24, Copyright (c) 2025 humoruniv.com All right reserved.